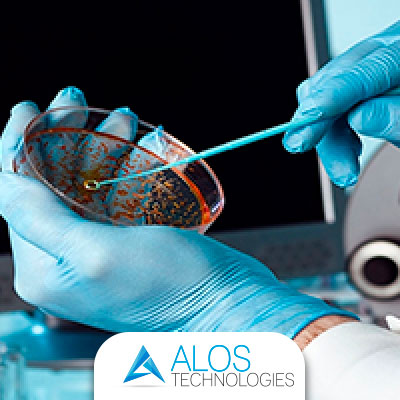
Monitoraggio microbiologico di ospedali e ambienti sanitari
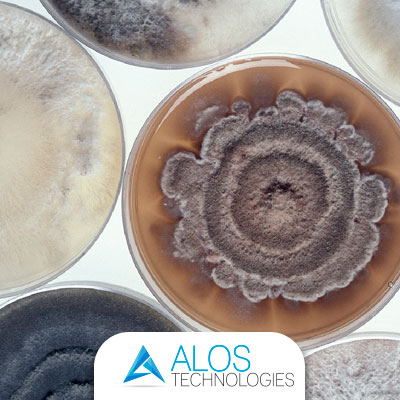
Tubazioni aria e Sick Building Syndrome ovvero la sindrome dell’edificio malato

Alos Technologies - ultime notizie
La sezione riporta le novità nei servizi e nelle attività di progettazione, di produzione e di commercializzazione dei dispositivi medici; di apparecchiature per i monitoraggi dei Gas e dell'ambiente. Un canale sempre puntato sulle più recenti scoperte dei sistemi nel settore della sanità, per una migliore informazione e conoscenza di tutti.
- Dettagli
- Scritto da Creare
Negli ambienti sanitari, soprattutto negli ospedali, non solo l’aria ma anche le superfici di attrezzature, piani, apparecchiature e indumenti di lavoro possono rappresentare fonti di contaminazione microbiologica.
Proprio per questo è evidente che occorre valutare e controllare costantemente il rischio di infezioni negli ambienti sanitari, principalmente negli ospedali.
Come?
Attraverso un monitoraggio microbiologico ambientale di aria e acqua ma anche delle superfici di sale operatorie, reparti ospedalieri e terapie intensive, che l’azienda Alos Technologies garantisce impiegando le migliori risorse, competenze e strumentalizzazioni.

- Dettagli
- Scritto da Creare
Nell’acqua erogata dalla rete municipale e, quindi, che arriva anche all’interno delle strutture ospedaliere sono presenti particelle contaminanti come sabbia, silice, residui ferrosi e alghe.
Tuttavia i metodi a disposizione per il controllo della diffusione di contaminanti negli impianti idrici sono numerosi. Tutti efficaci nel breve periodo ma non a lungo termine.
Infatti la maggior parte dei metodi di trattamento dell’acqua in diversi ambiti presentano limitazioni.
Questo è ancora più gravoso per quanto riguarda gli ambienti ospedalieri, visto il rischio di eventuali contaminazioni infettive dei pazienti.

- Dettagli
- Scritto da Creare
Nel settore della sanità pubblica e privata per quanto riguarda i servizi per ospedali pubblici e cliniche private un punto di riferimento è Alos Technologies.
Alos Technologies è un’azienda che opera al servizio della sanità pubblica e privata attraverso diverse attività e garantendo elevati standard di qualità su tutto il territorio nazionale.
Propone servizi che riguardano la distribuzione di dispositivi medici per l’utilizzo di gas medicinali, di apparecchiature per i monitoraggi dei gas e dell’ambiente, sanificazione di impianti HVAC, idrici e dell’aria e fornisce trattamenti anti-legionella.

- Dettagli
- Scritto da Creare
L’adozione dello standard ISO 13485 rappresenta un fondamento pratico per i produttori nell’affrontare le direttive sui dispositivi medici, i regolamenti e le responsabilità, dimostrando allo stesso tempo un impegno verso la sicurezza e la qualità delle apparecchiature mediche.
La norma ISO 13485 stabilisce i requisiti per un sistema di gestione della qualità specifico per l'industria dei dispositivi medici. È stata revisionata per rispondere ai più recenti sviluppi dei sistemi di gestione per la qualità, alle nuove tecnologie e ai requisiti legislativi associati a questo settore.
- Dettagli
- Scritto da Creare
La Sick Building Syndrome o “sindrome dell’edificio malato” è una patologia riconosciuta dall’Organizzazione Mondiale della Sanità (OMS) e riscontrata negli individui che passano molte ore in ambienti chiusi. La sindrome può causare irritazione della pelle e delle mucose, mal di testa, senso di secchezza dei bulbi oculari, difficoltà di concentrazione, cefalea, difficoltà respiratoria, sonnolenza.
Gli edifici, infatti, non sempre possono considerarsi habitat totalmente salubri e gli ambienti medici e ospedalieri, in particolare, sono considerati le aree più esposte agli agenti patogeni: umidità eccessiva, ventilazione inefficiente, basso comfort termico, polveri depositate possono contaminare la qualità dell’aria incidendo sulla salute delle persone che vi risiedono.

- Dettagli
- Scritto da Creare
Il motto, prevenire è meglio che curare, funziona sempre e soprattutto in molti campi della vita. Vale ancor di più se parliamo di prevenzione nel campo sanitario.
Una buona sanificazione nelle strutture ospedaliere sicuramente previene il rischio d’infezioni sia verso i pazienti, sia verso il personale preposto. Per evitare questi pericoli vanno effettuati degli interventi di disinfestazione, in alcuni casi, e di detersione in altri.
In tutti va eseguito un controllo costante ed efficiente da parte dei responsabili della sanificazione. Si deve infatti necessariamente ridurre la contaminazione di batteri di alcune superfici. I canadesi, nelle loro linee guida, sottolineano un chiaro criterio: ciò che non può essere pulito non deve essere acquistato.
